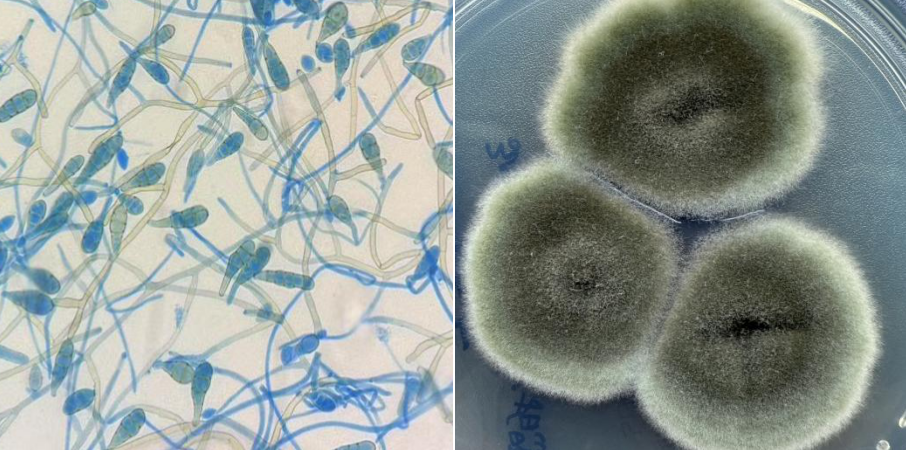

角膜是我们眼睛最外层的“透明盾牌”,一旦受伤或感染,视力就会受到严重影响。其中,有一种不容忽视的眼部疾病——真菌性角膜炎,因发病初期常被忽略,导致眼睛出现不可逆的损伤,甚至失明。今天,就让我们一起来认识一下这个“隐秘而凶狠”的敌人。
什么是真菌性角膜炎?
真菌性角膜炎,是一种由真菌侵入角膜组织引起的感染性眼病。它不是像普通感冒一样传播的“菌”,而是一类生活在自然环境中的微生物。
在临床中,根据病原性真菌侵犯部位不同,分为浅部真菌和深部真菌两类。根据真菌的菌落形态不同,又将真菌分为三种菌落形态:
1. 酵母样真菌:菌落光滑,奶酪样,不形成真、假菌丝,如常见的红酵母、隐球菌等;
2. 类酵母型菌落:菌落与酵母型相似,多数能形成假菌丝,如白色念珠菌等;
3. 丝状型真菌:菌落呈棉花状、绒毛状、海绵状或粉末状,有不同的颜色,通常由许多菌丝体组成,如曲霉菌、青霉菌、毛霉菌、链格孢菌属等;
(▲链格孢菌属分生孢子乳酸酚棉兰染色(左)及沙保平板菌落形态(右))
如何确诊?医生通常会做以下检查:
1.裂隙灯检查:通过裂隙灯观察患者角膜病灶情况进行初步判断;
2.角膜刮片+真菌染色:通过刮取患者角膜病灶溃疡物进行涂片染色,显微镜下观察是否有真菌菌丝及真菌孢子存在,进行进一步诊断。
3.角膜培养:在刮取患者角膜病灶溃疡物进行涂片时,同时做真菌培养,进一步明确具体真菌菌属;
4.前房穿刺(严重时):如果患者病情严重,可能需通过手术抽取眼内液进行相关检查,进一步了解感染程度;
如何预防真菌性角膜炎?
真菌性角膜炎发病慢,初期症状与普通细菌性角膜炎相似,如:眼红、眼痛、畏光、流泪、视力模糊等,临床病灶表现为角膜上有灰白色浸润或“羽毛状”边缘、溃疡灶干燥等,多见于农民、户外工作者。
如在户外进行农作物耕种时,注意眼部保护,及时冲洗异物;佩戴隐形眼镜者应定期清洁、更换隐形眼镜;如有眼外伤,应及时就医检查,不要随意使用抗生素或激素类眼药。
由于真菌性角膜炎发病早期无明显症状,很容易让大家忽视,导致病情加重,严重导致角膜穿孔,所以请大家一定要及时就医。
长沙爱尔眼科医院医学检验科提醒:真菌性角膜炎虽然不是常见病,但一旦发生,危害极大。大家应提高防范意识,特别是在眼外伤、免疫低下、隐形眼镜佩戴者等高危人群中,眼睛有事,要重视!让我们保护好心灵的窗户!
湖南医聊特约作者:李珊
关注@湖南医聊,获取更多健康科普资讯!
(编辑92)
来源: 李珊
科普中国公众号
科普中国微博

帮助
湖南医聊